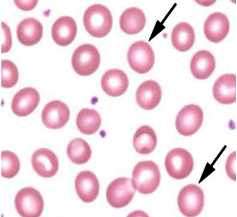
Razmaz periferne krvi

ERITROCITI
1. KRVOTVORNI SISTEM
U krvotvorni sistem, odnosno hematopoetsko tkivo spadaju: koštana
srž, timus, limfni čvorovi i slezena.
Koštana srž je meko spužvasto tkivo unutar kosti, a nalazi se u zdjeličnoj
kosti, grudnoj kosti, kičmenom stubu, rebrima i kostima lubanje, i sadrži
stanice koje proizvode krvne stanice. U koštanoj srži se proizvede oko
95% ljudskih krvnih stanica, a svaka od proizvedenih krvnih stanica ima
vitalnu ulogu za održavanje života.
Svaki dan koštana srž proizvede 10 /13 stanica različitih
loza, a tri su glavna tipa krvnih stanica proizvedenih u koštanoj srži:
- Crvena krvna zrnca -eritrociti: nose
kiseonik u tkiva, žive nekoliko sedmica
- Bijela krvna zrnca - leukociti : pomažu
u borbi protiv infekcije i dodatak su imunom sistemu, žive nekoliko dana
- Krvne pločice-trombociti : pomažu
zgrušavanje krvi, žive nekoliko sati.
Najmanje zrele su prastanice ili pluripotentne matične stanice koje čine
0,01-0,05% stanica koštane srži i ishodišne su stanice za 9 funkcionalno
zrelih stanica. Diferencijacijom matične ćelije histogenetski razlikujemo:
MIJELOPOEZU (hematopoeza u užem smislu): stvaranje eritrocita, granulocita,
monocita, trombocita u samoj koštanoj srži
IMUNOPOEZU: stvaranje limfocita i plazma ćelija u koštanoj srži, uz daljnju
diferencijaciju, sazrijevanje i proliferaciju u timusu, limfnim čvorovima
i/ili slezeni.
Diferencijacijom od pluripotentne matične stanice nastaje multipotentna
matična stanica iz kojih se dalje razvijaju mijelopoetske loze, i to tako
da u zadnjem stadiju diferencijacije od multipotentnih stanica nastaju
unipotentne matične stanice, koje imaju karakteristične fenotipske odlike
za određene loze.
U regulaciji procesa hematopoeze učestvuje niz hematopoetskih faktora
rasta - citokina, koje stvaraju stanice strome koštane srži, i to:
- KIT-ligand (SCF) usmjerava primitivne matične stanice
u odgovarajuću hematopoetsku lozu
- Interleukin usmjerava primitivnu mijeloidnu matičnu
stanicu u odgovarajuću mijelopoetsku lozu
- Eritropoetin, G-CSF i M-CSF stimuliraju eritro-,granulo-
i monocitopoezu
2. ERITROCITI
Eritrociti, ili kako se često nazivaju, crvena krvna
zrnca su takve stanice čija je osnovna zadaća
prijenos hemoglobina koji tkivma donosi kisik iz pluća i odnosi CO2 iz
tkiva. Ta reakcija ide tako da se kisik veže sa hemoglobinom kod
visokog pO2 u plućima, pri čemu nastaje oksihemoglobin, koji pri nižim
pO2 u tkivima otpušta kisik. Također obratno, u tkivima se, u toku metabolizma
stvoreni CO2 većim dijelom veže za hemoglobin, te tako, putem pluća, biva
eliminiran van.
Hemoglobin se sintetizira u toku eritropoeze; počinje još u proeritroblastima,
a traje još nekoliko dana nakon što stanice napuste koštanu srž.
Zanimljivo je da su eritrociti takve stanice koje ne posjeduju nukleus,
a imaju i preveliku membranu u odnosu na sadržaj stanice, što je vrlo
značajno jer omogućuje eritrocitu mijenjanje oblika pri prolazu kroz kapilare,
ali bez rastezanja membrane i pucanja eritrocita. Inače, normalni eritrociti
su bikonkavne pločice koje imaju prosječan promjer oko 8 цгп.
Na slici 1 prikazan je razmaz periferne krvi, a eritrociti su obilježeni
strelicama.
2. 1. RAZVOJ ERITROCITA
Kako je već u uvodu navedeno, u koštanoj srži se nalaze
pluripotentne hematopoetske matične stanice od kojih nastaju sve ostale
stanice u cirkulirajućoj krvi.

Na slici 2 šematski je prikazana hematopoeza,
počev od pluripotentne matične stanice, pa do razvoja zrelih krvnih stanica.
Dakle, iz pluripotentne matične stanice diferencijacijom nastaje multipotentna
iz koje dalje nastaje unipotentna matična stanica. Daljnjim sazrijevanjem
nastaje proeritroblast koji je prva prepoznatljiva mlada ćelija eritrocitne
loze, a naziva se još i pronormoblastom. On se dalje dijeli još četiri
puta i daje 16 zrelih eritrocita. Prijelazne faze su bazofilni, polihromatofilni
i acidofilni eritroblasti. Bitno je napomenuti da se hemoglobin počinje
sintetizirati još u fazi proeritroblasta i nastavlja se tokom svih dalje
navedenih faza. Tako mladi bazofilni eritroblasti sadrže više RNA, dok
zreliji eritroblasti sadrže više hemoglobina. Prva zrela ćelija koja dospijeva
u cirkulaciju je retikulocit u kome se nalaze još samo zrnca preostale
RNA. CFU-E (colony forming unit - erytrocyte) predstavlja stadij usmjerene
matične stanice od koje potiču eritrociti, prije stadija proeritroblasta,
a nakon BFU-E (burst forming unit -erytrocyte).
Rast i diobu različitih matičnih stanica nadziru mnoge bjelančevine koje
nazivamo induktori rasta, od kojih je interleukin jedan od ukupno četiri
opisana. Njegova uloga je da potiče rast svih vrsta matičnih ćelija, dok
su ostala tri zadužena za indukiju rasta samo specifičnih vrsta usmjerenih
matičnih ćelija, kako je i navedeno u uvodu Osim induktora rasta, postoje
bjelančevine koje potiču diferencijaciju stanica, te se nazivaju induktori
diferencijacije. Dejstvo induktora rasta i diferencijacije vrlo je značajno
jer se uz njihovu pomoć kontroliše produkcija različith stanica krvi,
a u ovisnosti o faktorima izvan koštane srži.
2. 2. HORMONSKA REGULACIJA ERITROPOEZE
Kako je već pomenuto, na produkciju krvnih stanica utiču faktori van
koštane srži. Konkretno, u slučaju eritropoeze, glavnu ulogu u tom smislu
ima oksigenacija tkiva, što je i logično obzirom da osnovna uloga eritrocita
i jeste oksigenacija tkiva. Stoga, svako stanje koje uzrokuje smanjenje
količine kisika prenesenog u tkiva povećava brzinu produkcije eritrocita.
Ovo važi za situacije u kojima je došlo do anemije, bilo uslijed krvarenja
ili nekog drugog uzroka, a također i u slučaju nedostatka kisika u vanjskoj
sredini, npr. na velikim nadmorskim visinama. U ovakvim ili sličnim situacijama,
gdje dolazi do oslabljene opskrbe tkiva oksigenom, organizam reaguje povećanom
i ubrzanom produkcijom eritrocita, a veliku ulogu u tome igra hormon eritropoetin.
To je glikoprotein koji nastaje najvećim dijelom u bubrezima (80-90%)
i manjim dijelom u jetri. On kontroliše najveći dio proliferativnih procesa
i sazrijevanja eritroidne loze. Produkcija eritropoetina je direktno ovisna
o stepenu opskrbljenosti tkiva kisikom, tako da hipoksija uzorkuje izrazit
porast proizvodnje eritropoetina, dok će, s druge strane, policitemija
(izazvana transfuzijom u eksperimentu) dovesti do smanjenja produkcije
eritropoetina. Također, u slučaju nedostatka eritropoetina, hipoksija
nema nikakav ili ima vrlo mali učinak u poticanju proizvodnje eritrocita.
2. 3. SAZRIJEVANJE ERITROCITA
Za konačno sazrijevanje eritrocita veoma su važna dva vitamina, i to
vitamin B12 i folna kiselina. Osim navedenih vitamina, da bi eritrocit
ispunio svoju osnovnu ulogu opskrbe tkiva kisikom, veoma je bitna sinteza
hemoglobina koja se odvija u raznim stadijima njegovog razvoja i sazrijevanja,
a pri tome vrlo značajnu ulogu ima i metabolizam željeza. Nedostatak ili
nemogućnost iskorištenja bilo koje od navedenih tvari ili elemenata dovodi
do bolesti crvene loze u vidu raznih vrsta anemija.
2. 3. 1. Vitamin B12
Vitamin B12 - kobalamin ili cijanokobalamin je kompleksni hemijski spoj
čija je hemijska struktura slična hemoglobinu samo što je umjesto željeza
u njemu vezan kobalt. Nalazi se u mesnim namirnicama pa se njegov deficit
često sreće kod osoba koje ne konzumiraju mesne namirnice. Apsorbcija
vitamina B12 se odigrava u ileumu tako da se veže sa jednim glikoproteinom
nazvanim «unutrašnji faktor» (intrinsic factor) kojeg luče sluzne žlijezde
kardije želuca. Tako vezan, ovaj je vitamin zaštićen od tjelovanja probavnih
enzima, pa taj kompleks veže ione kalcija.Dalje se veže na specifična
receptorska mjesta mukoznih epitelnih stanica ileuma, odakle se procesom
pinocitoze transportuje kroz stanične membrane.
Biološka funkcija vitamina B12 je da služi kao koenzim nekim enzimima,
gdje između ostalog, učestvuje u pretvorbi ribonukleotida u dezoksiribonukleotide,
pa u slučaju njegovog nedostatka dolazi do smanjenja količine DNA i posljedičnih
poremećaja sazrijevanja i diobe jezgre stanica.10 U ovom slučaju deficit
vitamina B12 uzrokuje pernicioznu anemiju gdje se uočava smanjena aktivnost
enzima ribonukleotid reduktaze kojoj nedostaje koenzim, pa se smanjuje
količina DNA.
Najčešći uzrok deficita ovog vitamina je defekt u izlučivanju unutrašnjeg
faktora, što onemogućuje apsorbciju B12 vitamina.
Budući da organizam čuva svoje zalihe vitamina B12, prvenstveno u jetri,
i da su te količine dovoljne za oko 3 godine, anemija uslijed deficita
ovog vitamina neće nastupiti prije tog
2. 3. 2. Folna kiselina
Folna se kiselina u organizam unosi također putem gastrointestinalnog
trakta, a za njenu sintezu su većinom odgovorne crijevne bakterije.
Biološka funkcija folne kiseline jeste da služi kao koenzim nekih enzima
u metaboličkim procesima, između ostalih i biosintezi purina i pirimidina,
te sintezu timina potrebnog za sintezu DNA, pa se u slučaju njenog nedostatka
koči sinteza hemoglobina i sazrijevanje eritrocita. Obzirom na navedeno
vrlo je lako uvidjeti zašto njen deficit uzrokuje slične poremećaje kao
i deficit vitamina B12. U nedostatku folne kiseline u organizmu javlja
se makrocitna megaloblastna anemija.
2. 3. 3. Metabolizam željeza
Ljusdki organizam sadrži oko 4-5g željeza, od čega se najveći dio nalazi
vezan u hemoglobinu (do 70%).10 Željezo se u organizam unosi putem hrane
i biva apsorbirano u duodenumu i jejunumu, a kako njegova apsorbcija zavisi
od mnogo faktora, potrebno je da hrana sadrži više željeza nego što su
dnevne potrebe organizma. Faktori od kojih zavisi apsorbcija željeza su:
eritropoetska aktivnost koštane srži, pO2, popunjenost skladišta u RES
(retikuloendotelni sistem), valenciji željeza i pH sredine gdje se vrši
apsorbcija.Želučani sok stvara pogodnu kiselu sredinu za redukciju trovalentnog
željeza (samo dvovalentno željezo biva apsorbovano), te se kod osoba sa
hipoaciditetom ili anaciditetom želučanog soka javlja loša apsorbcija
željeza. Apsorbciji također pogoduje i askorbinska kiselina tako što djeluje
kao reducens.
Željezo se nakon apsorbcije odmah veže u krvnoj plazmi za betaglobulin
apotransferin pri čemu nastaje transferin koji se prenosi plazmom, a krvlju
dolazi do stanica RES-a gdje se skladišti kao feritin - rezervno željezo.
U slučaju potrebe, željezo se oslobađa iz feritina i ponovo veže za transferin,
te tako biva transportovano krvlju. Transferin ulazi direktno u eritroblaste
i otpušta željezo direktno u mitohondrije, gdje ono ulazi u sintezu hema.
2. 3. 4. Sinteza hemoglobina
Biosinteza hema koja se odvija dijelom u mitohondrijima, a dijelom u
citoplazmi je prilično komplikovan biohemijski proces. Ukratko, ovdje
se željezo preneseno transferinom ugrađuje u molekulu hema, nakon čega
se hem vezuje na polipeptidne lance hemoglobina, kojih ima četiri, i to
tako da je svaki hem vezan za jedan polipeptidni lanac hemoglobina. Bitno
je napomenuti da hemoglobin jedini stvara stabilni kompleks u kom željezo
i nakon vezanja sa kisikom ostaje dvovalentno, što je rezultat položaja
hema u molekuli hemoglobina. Stoga je jasno da svaka molekula hemoglobina
može prenijeti ukupno četiri molekule (osam atoma) kisika. Osim uloge
vezanja kisika, a koja je već ukratko objašnjena u uvodu; hemoglobin ima
i posredno važnu ulogu kao pufer u održavanju acido-bazne ravnoteže u
organizmu.
Poremećaji u biosintezi hema najčešće su u vidu porfirija, porfirinurije
i porfirinemije, Porfirije su hereditarni poremećaji, a mogu biti eritropoetske
i hepatične, dok su porfirinurija i porfirinemija nespecifični i prate
neka patološka stanja u organizmu.
Također, određeni poremećaji u biosintezi hemoglobina i sinteza patoloških
hemoglobina u vezi su sa nekim hereditarnim anemijama. Te pojave patoloških
hemoglobina su nasljedne i nazivaju se hemoglobinopatijama, a one mogu
i ne moraju izazvati kliničke promjene ovisno o nasljeđivanju. Takva je
na primjer bolest srpastih stanica (sicle cell). Još jedna nasljedna bolest
je talasemija (mediteranska anemija) gdje se zapravo ne radi o strukturno
promijenjenim polipeptidnim lancima nego je suština da se hemoglobim manje
sintetizira. Ovdje dolazi do pojave eritrocita koji imaju izgled cilja
(target cells) sa mikrocitozom, hipokromijom i poikilocitozom.
2. 4. RASPADANJE ERITROCITA
Nakon što eritrocit sazrije i dospije u krvotok, on normalno cirkuliše
oko 120 dana. Naime, eritrociti su takve stanice koje nemaju nukleusa,
endoplazmatskog retikuluma i ostale strukture kao druge stanice u organizmu,
te stoga nisu sposobne podržati metaboličke procese. Ipak, bez obzira
na to, u njihovoj citoplazmi se nalaze određeni enzimi uz pomoć kojih
se može proizvoditi mala količina ATP iz glukoze. Međutim ova količina
ATP nije dostatna da bi podržala duže trajanje eritrocita kao ćelije,
što između ostalog dovodi do gubitka elastičnosti stanične membrane, te
posljedičnog prskanja eritrocita pri prolasku kroz suženo mjesto u cirkulaciji.
Mnogi se eritrociti raspadaju pri prolasku kroz crvenu pulpu slezene,
koja služi kao svojevrstan filter, jer je promjer njenih strukturnih trabekula
mnogo uži nego promjer eritrocita. Nakon što se eritrocit raspadne makrofagi
fagocitiraju taj materijal, većinom u jetri, slezeni i koštanoj srži.
Iz fagocitiranog hemoglobina oslobađa se željezo natrag u krv, koje se
prenosi transferinom i biva upotrebljeno za sintezu hema i hemoglobina
ili se u vidu feritina skladišti. Ostatak, tj. porfirinski dio hemoglobinske
molekule se u nekoliko faza pretvara u bilirubin koji se otpušta u krv
i jetrom izlučuje u žuč.
ZAKLJUČAK
Eritrociti su crvene krvne stanice koje nastaju u koštanoj srži, čija
je glavna funkcija transport kisika i odstranjivanje ugljičnog dioksida
nastalog u toku metaboličkih procesa u tkivima organizma. Proces stvaranja
eritrocita naziva se eritropoeza i uslovljen je potrebama organizma za
kisikom. Dakle u situacijama gdje je prisutan nedostatak kisika, bilo
da je ovaj uzrokovan uvjetima u vanjskoj sredini (velika nadmorska visina)
ili unutrašnjim faktorima (anemija, krvarenje, bolesti respiracijskog
sistema i sl.), dolazi do povećane i ubrzane produkcije crvenih krvnih
stanica. Također, eritropoeza je hormonski uvjetovana i pod direktnim
utjecajem hormona eritropoetina kojeg luče najvećim dijelom bubrezi. Ipak
za normalan rast i razvoj eritrocita u toku eritropoeze od velikog su
značaja i neki vitamini (B12 i folna kiselina), a kako je željezo odgovorno
za vezanje kisika u hemoglobinsku molekulu i njegov prenos putem eritrocita
do stanica i tkiva, vrlo je bitan i metabolizam ovog elementa. Budući
da je eritropoeza ovisna o mnogim navedenim faktorima moguća je pojava
velikog broja bolesti crvene loze, počev od sideropenične anemije uzrokovane
nedostatkom željeza ili krvarenjem pa do nekih nasljednih genetskih poremećaja
koji nekad i ne moraju izazvati kliničke promjene.
L I T E R A T U R A
1. Gyton A.C. "Medicinska fiziologija"
2. Štraus B. "Medicinska biohemija", Zagreb 1988.g.
3. Fajgelj A., Grujić M., Macanović M., Mikeš A., Numić N., Pašić I.
"Interna medicina II — Endokrinologija, hematologija, kardiologija,
osnovi kliničke imunologije, bolesti lokomotornog aparata i veziva,
egzogena trovanja", I izdanje, Sarajevo 1986.g.
4. Slike i ilustracije preuzete sa: http://en.wikipedia.org/wiki/Hematopoietic
PROČITAJ
/ PREUZMI I DRUGE SEMINARSKE RADOVE IZ OBLASTI:
|
|
preuzmi
seminarski rad u wordu » » »
Besplatni
Seminarski Radovi
|